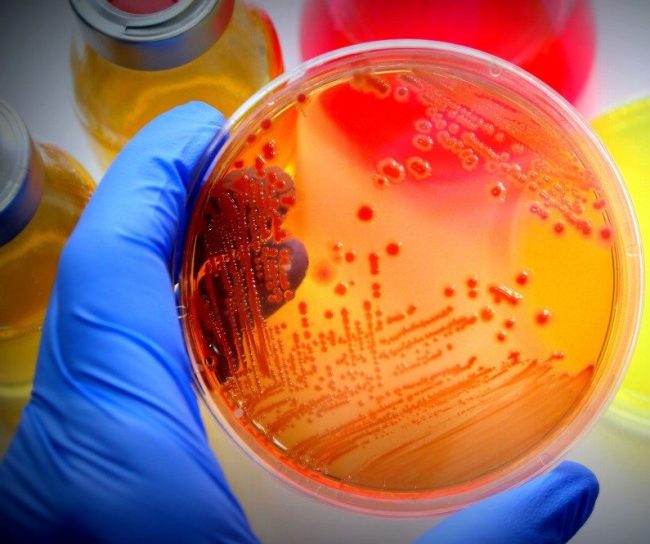
Vårt ansvar - Antibiotika - MSD Sverige

Ansvar
Vårt uppdrag att rädda och förbättra liv, inspirerar oss att springa till, inte från, världens största hälsoutmaningar. Vi lever våra kärnvärden för hållbar utveckling genom att hantera vår verksamhet ansvarsfullt.
Vi strävar efter att hitta lösningar för några av världens allvarligaste sjukdomar, efter att nå de i nöd med våra läkemedel och vacciner och hjälpa till att bygga robusta, hållbara hälso– och sjukvårdsystem.
Vi gör detta i hela världen genom partnerskap, investeringar och innovation.
Stödjer Agenda 2030
Vi har en viktig roll att spela för att hjälpa till att ta itu med FN: s mål för hållbar utveckling och vi vill gärna hitta sätt att bidra till samhället samtidigt som vi stärker vår verksamhet.
Våra ansträngningar är främst inriktade på SDG3 – Good Health and Wellbeing, som är anpassad till vår kärnverksamhet och vårt uppdrag att rädda och förbättra liv.
Några exempel på globala donationsprogram som vi är engagerade i är flodblindhet, ebola och mödradödlighet.
Svensk pilot först i världen
Antibiotikaresistens är ett allvarligt globalt hälsohot som ökar i omfattning.
Vi är ett av få företag som fortsätter att investera i utvecklingen av nya antibiotika. Dessutom deltar vi i flera globala program för att främja utvecklingen av nya antibiotika och antibiotika-alternativ för att bekämpa resistens.
Vi deltar även i världens första pilotstudie som ska utvärdera en ny betalningsmodell för utvalda antibiotika, initierad av folkhälsomyndigheten i Sverige. Målet är att säkra tillgången på viktiga antibiotika för patienter med svårbehandlade infektioner med multiresistenta bakterier.

MSD for Mothers
MSD for Mothers är vårt tioåriga initiativ om 500 miljoner dollar för att minska mödradödligheten i världen. Visionen är att skapa en värld där ingen kvinna ska dö för att hon ger liv.
Vi förbättrar mödrar hälsa genom att:
- stärka kvinnor
- utrusta och utbilda de som vårdar
- stärka och förbättra vårdsystem
Vi är övertygade om att vi kan få ett slut på mödradödligheten men vi kan inte göra det själva. Tillsammans startar vi program, partnerskap och lösningar för världens mammor. Hittills har våra program nått mer än 11 miljoner kvinnor i 48 länder runt om i världen.

Mectizan Donation Program
Flodblindhet orsakas av parasiter och ger ihållande, plågsam klåda, allvarliga hudförändringar och efter hand blindhet. Sjukdomen finns i 35 länder, främst i Afrika och Centraloch Sydamerika.
1987 beslutade MSD att donera läkemedlet Mectizan mot flodblindhet till alla som behöver det så länge det behövs. The Mectizan Donation Program (MDP) bildades.
MDP är världens största pågående donationsprogram och hittills har över 3,4 miljarder behandlingar donerats till 44 länder i Afrika, Latinamerika, Mellanöstern, Asien och Stillahavsområdet.
I fyra latinamerikanska länder – Colombia, Ecuador, Mexiko och Guatemala – har flodblindhet eliminerats. Lymfatisk filariasis har eliminerats i Togo, Jemen och Malawi.
Upptäckten bakom Mectizan gjordes av vår forskare Dr. William Campbell som därför tilldelades Nobelpriset i medicin 2015.

Vårt arbete mot Ebola
Ebolautbrottet i Västafrika 2014–2016 var det största och mest komplexa i sjukdomens historia. Nya utbrott rapporterades under 2018 i Demokratiska Republiken Kongo.
Tillsammans med Världshälsoorganisationen, Läkare utan gränser, Kongos regering och hälsomyndigheter arbetade forskare från MSD för att minska omfattningen av utbrottet.
MSD bidrar med vaccin och personal ochre kunde tillsammans med många andra stävja flera utbrott av sjukdomen som skördat över 11000 liv.

Vårt miljöarbete
En frisk planet är helt avgörande för människors hälsa och hållbarheten i vår verksamhet. Våra handlingar har en direkt inverkan på vår planet och vi prioriterar hållbarhetsstrategier för att minska miljöpåverkan i vår verksamhet.
Under 2021 lanserade vi en ny uppsättning miljömål – för att reducera vårt koldioxidutsläpp och därmed bidra till att minska de värsta effekterna av klimatkrisen. Vi har som mål att göra vår verksamhet koldioxidneutral till år 2025, och att uppnå en 30 procentig minskning av utsläpp i hela värdekedjan till 2030.
Allt vi gör, inom såväl hälsa som miljö, bygger på vetenskap. Därför står också bakom målen i Parisavtalet och vi gör allt vi kan för att nå FN:s hållbarhetsmål, bland annat FN:s klimatmål.